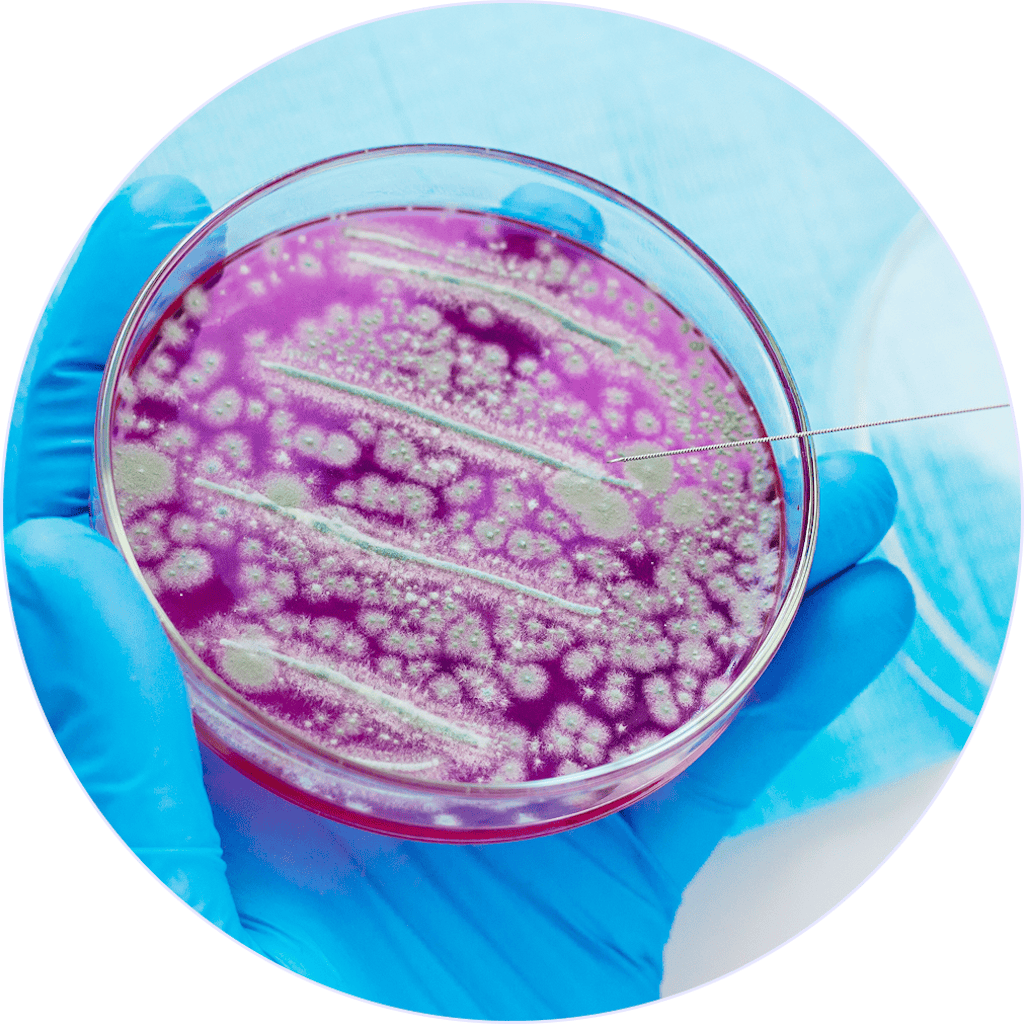
Szczepy probiotyczne

Dla utrzymania równowagi mikrobioty jelitowej kluczowe znaczenie ma dieta i zdrowy styl życia, uwzględniający zarządzaniem stresem, odpoczynek i aktywność fizyczną. Suplementacja probiotyków może stanowić dodatkowe wsparcie.
Dbamy o komfort Twoich jelit.
1️⃣ Dopiero rozpoczynasz przygodę z probiotykami? Na dobry start szczególnie polecamy ProbioticMe.
2️⃣ Stosowałaś już wcześniej probiotyki i potrzebujesz bardziej zaawansowanego działania? Wypróbuj ProbioticMe Advanced.
➡️ W stosowaniu probiotyków kluczowa jest regularność! Rekomendujemy 3-miesięczną suplementację dla najlepszych rezultatów. Pamiętaj, aby rotować probiotyki w celu zachowania odpowiedniej różnorodności mikrobiomu.
Suplement diety ProbioticMe przeznaczony jest dla osób dorosłych.
ProbioticMe Day
1 kapsułka dziennie, rano
— po posiłku
ProbioticMe Night
1 kapsułka dziennie, wieczorem
— po posiłku
Nie należy przekraczać zalecanej dziennej porcji. Zrównoważony sposób żywienia i zdrowy tryb życia jest ważny dla funkcjonowania organizmu człowieka. Suplement diety nie może być stosowany jako substytut (zamiennik) zróżnicowanej diety.
Wyselekcjonowane szczepy bakterii
Formuła Day&Night
Z błonnikiem akacjowym o działaniu prebiotycznym
Probiotyk dla dorosłych połączony z prebiotykiem
60 kapsułek (29,7 g)
wspiera różnorodność mikrobioty jelitowej (bakterie probiotyczne)
polecany także w trakcie i po przyjmowaniu antybiotyków
Poznaj suplement diety ProbioticMe

[dot] Zawiera wyselekcjonowane szczepy bakterii i drożdży, które wspierają mikrobiotę jelitową i procesy trawienne.
[dot] Chroni jelita przed rozwojem bakterii chorobotwórczych i wspiera ich naturalną odporność.
[dot] Formuła z kapsułkami Day & Night zawierającymi szczepy o celowanym działaniu zapobiega wzajemnemu neutralizowaniu składników.
[dot] Regularne stosowanie sprzyja równowadze flory jelitowej i lepszemu wchłanianiu składników odżywczych.
[dot] Zawiera wyselekcjonowane szczepy bakterii i drożdży, które wspierają mikrobiotę jelitową i procesy trawienne.
[dot] Chroni jelita przed rozwojem bakterii chorobotwórczych i wspiera ich naturalną odporność.
[dot] Formuła z kapsułkami Day & Night zawierającymi szczepy o celowanym działaniu zapobiega wzajemnemu neutralizowaniu składników.
[dot] Regularne stosowanie sprzyja równowadze flory jelitowej i lepszemu wchłanianiu składników odżywczych.
Jelita oddziałują na nasz cały organizm
"Mikrobiota jelitowa odgrywa kluczową rolę w prawidłowym funkcjonowaniu całego naszego organizmu. Wpływa korzystnie na funkcje przewodu pokarmowego, a nawet może mieć istotne znaczenie w utrzymaniu dobrego samopoczucia. Probiotyki stanowią dla naszych jelit tzw. “osłonę” i uzupełniają skład mikrobioty, zwłaszcza gdy jej równowaga jest zachwiana przez długotrwały stres czy antybiotyki."
Synbiotyk dla komfortu jelit
Suplement diety ProbioticMe to synbiotyk, czyli połączenie probiotyku z prebiotykiem (błonnik akacjowy INAVEA™ PURE ACACIA), który stanowi dla bakterii źródło energii do wzrostu. Dzięki temu bakterie, które dostarczasz swoim jelitom aktywniej wspierają trawienie i dobrostan całego organizmu.
Dbasz o mikrobiom? Tego nie powinno zabraknąć w Twojej diecie
Nie tylko kiszonki oraz fermentowane produkty mleczne są korzystne dla naszej mikrobioty. Pamiętaj o produktach bogatych w błonnik, takich jak warzywa i owoce, ale również orzechy czy kasze i produkty pełnoziarniste.
Potrzebujesz pomocy? Jesteśmy dla Ciebie.
Porozmawiaj z naszym zespołem obsługi klienta. Od poniedziałku do piątku od 8:00 do 21:00.